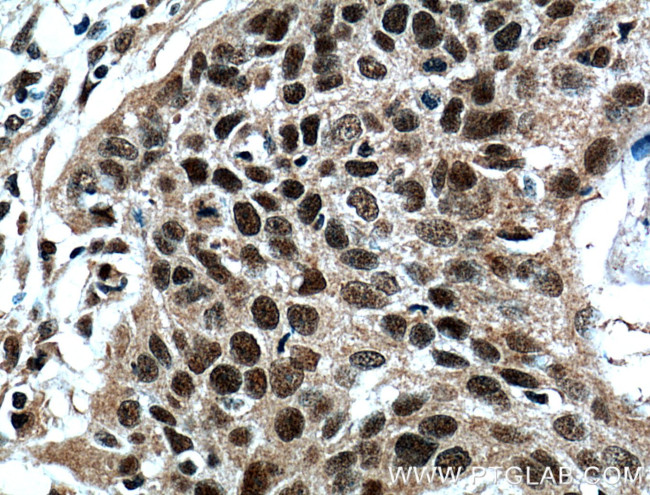
ZNF750 Antibody in Immunohistochemistry (Paraffin) (IHC (P))

Search
Proteintech
ZNF750 Polyclonal Antibody
{{$productOrderCtrl.translations['antibody.pdp.commerceCard.promotion.promotions']}}
{{$productOrderCtrl.translations['antibody.pdp.commerceCard.promotion.viewpromo']}}
{{$productOrderCtrl.translations['antibody.pdp.commerceCard.promotion.promocode']}}: {{promo.promoCode}} {{promo.promoTitle}} {{promo.promoDescription}}. {{$productOrderCtrl.translations['antibody.pdp.commerceCard.promotion.learnmore']}}
产品信息
21752-1-AP
种属反应
宿主/亚型
分类
类型
抗原
偶联物
形式
浓度
规格
纯化类型
保存液
内含物
保存条件
运输条件
产品详细信息
Immunogen sequence: HVEFESPIP EAKDSSKAGQ RDTEGSKMSP RAGSAATGSP GRPSPTDFMQ TSQTCEGLYD LSNKAASSAL GRLYPPEQSL TAFRPVKKST ECLPAQAAET TAESPVSLNV VNGDPPAPTG SASLVSEAAP SSPDDSSGMG PLNLSKKSEI NLAATHEPTY QGSPQAETAS FSELQDLPLN LSVKDPCNTQ APRPAFPGRP RAAEPAAAVP QKTGTEGSED GPSHPETKPG SLDGDGAPPT GPGEEAPDAC AVDSSEEQKQ TAAVALCQLA AYSPRNIRVG DGDAAAPEPA CRQDTPTLSS MESQEAQCDL RPKGQKRTSL RDAGKSQQGA KKAKLQDTAR VFTLRRRARV S (374-723 aa encoded by BC109037)
靶标信息
Zinc finger protein 750 is a new candidate transcription factor.
仅用于科研。不用于诊断过程。未经明确授权不得转售。
生物信息学
蛋白别名: protein ZNF750; unnamed protein product; Zinc finger protein 750
基因别名: A030007D23Rik; SLDPE; ZFP750; ZNF750
UniProt ID: (Human) Q32MQ0, (Mouse) Q8BH05
Entrez Gene ID: (Human) 79755, (Mouse) 319530